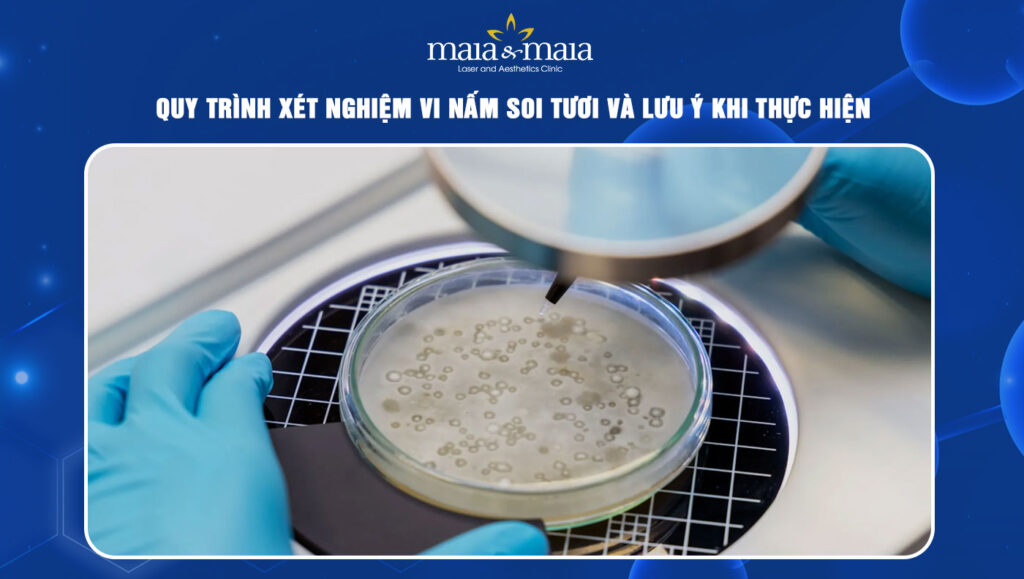
Vi nấm soi tươi

Vi nấm soi tươi là xét nghiệm quan trọng được chỉ định trong hầu hết các tình trạng nhiễm trùng do nấm gây ra nhằm chẩn đoán chính xác và đảm bảo kết quả điều trị tối ưu. Vậy khi nào nên thực hiện xét nghiệm này và cần lưu ý gì? Cùng Phòng khám Chuyên khoa Da liễu Maia&Maia tìm hiểu thông tin chi tiết qua nội dung bài viết sau.
I. Vi nấm soi tươi là xét nghiệm gì?
Vi nấm soi tươi hay KOH test là kỹ thuật sử dụng dung dịch kiềm KOH để làm mềm mô sừng ở vùng da có triệu chứng giúp bác sĩ xác định sự hiện diện của vi nấm và dễ dàng quan sát cấu trúc nấm dưới kính hiển vi.
Xét nghiệm này được chỉ định bởi thao tác thực hiện đơn giản, nhanh chóng với độ chính xác cao. Từ đó, bác sĩ sẽ phân biệt bệnh nấm da với các bệnh lý có biểu hiện tương tự và xây dựng phác đồ điều trị phù hợp để hạn chế rủi ro dùng thuốc kéo dài mà không đúng tình trạng.
- Ưu điểm: Kỹ thuật đơn giản, dễ thực hiện tại hầu hết cơ sở da liễu cho kết quả nhanh chóng chỉ trong vài phút và chi phí xét nghiệm thấp
- Nhược điểm: Không xác định chính xác loại nấm như nuôi cấp, độ chính xác phụ thuộc vào kỹ thuật lấy mẫu và kinh nghiệm của bác sĩ hoặc kỹ thuật viên

II. Khi nào cần xét nghiệm vi nấm soi tươi?
Xét nghiệm vi nấm soi tươi được thực hiện khi có các dấu hiệu lâm sàng nghi ngờ nhiễm nấm hoặc cần xác định chẩn đoán nhanh chóng, cụ thể:
- Da xuất hiện dấu hiệu nghi nhiễm nấm với cảm giác ngứa dữ dội, bề mặt da bị bong vảy, đỏ rát, nổi mụn nước hoặc tổn thương lan rộng
- Tổn thương không cải thiện sau khi dùng kem bôi thông thường hoặc tái phát nhiều lần
- Nghi ngờ nấm móng, nấm tóc, nấm bẹn, nấm kẽ hoặc nấm thân mình sau thăm khám lâm sàng
- Cần kết quả xác định nhiễm nấm trước khi bắt đầu điều trị bằng thuốc kháng nấm đường uống
- Phân biệt với những bệnh lý da liễu có biểu hiện tương tự như vảy nến, viêm da cơ địa, chàm,…
Ngược lại, mọi người không nên thực hiện xét nghiệm vi nấm soi tươi trong những trường hợp sau để tránh kết quả sai lệch hoặc không cần thiết về mặt lâm sàng:
- Vùng tổn thương đang chảy máu, nhiễm trùng nặng hoặc bị trợt loét khiến việc lấy mẫu kém chính xác
- Đã sử dụng thuốc kháng nấm hoặc kháng sinh lên vùng da nghi ngờ trong vòng 24 – 48 giờ dễ gây âm tính giả
- Các trường hợp bác sĩ xác định đây không phải bệnh do nấm thông qua tổn thương điển hình
- Trẻ nhỏ không hợp tác trong quá trình lấy mẫu

III. Quy trình tiến hành soi tươi vi nấm chuẩn y khoa
Soi tươi vi nấm đòi hỏi thao tác chính xác để thu được mẫu bệnh phẩm đúng vị trí và đủ số lượng. Do đó mọi người cần tuân thủ quy trình thực hiện gồm các bước sau để hạn chế sai sót trong chẩn đoán:
1. Chuẩn bị và lấy mẫu
Dựa theo vị trí nghi ngờ nhiễm nấm, bác sĩ thao tác lấy mẫu bệnh phẩm phù hợp để quan sát sợi và bào tử nấm rõ nhất thông qua kính hiển vi:
- Da: Dùng dao y khoa chuyên dụng để cạo nhẹ ở rìa tổn thương chứa khuẩn nấm hoạt động mạnh mẽ
- Kẽ ngón chân, tay: Lấy vảy trắng hoặc chất ẩm tích tụ tại vị trí tổn thương thường chứa nhiều bào tử nấm
- Móng: Cạo vụn móng, bề mặt móng và phần sừng bên dưới móng
- Tóc: Nhổ sợi gãy, tóc đục màu hoặc lấy vảy tại chân tóc nghi ngờ nhiễm nấm
- Vùng bẹn hoặc thân mình: Cạo lớp vảy mỏng ở rìa ngoài tổn thương để tăng độ chính xác
2. Xử lý mẫu bệnh phẩm
Sau khi hoàn tất thu bệnh phẩm, bác sĩ đặt mẫu lên lam kính và nhỏ dung dịch KOH 10 – 20% rồi đợi vài phút để phá vỡ keratin mà không ảnh hưởng đến cấu trúc nấm, từ đó giúp sợi nấm, bào tử hiện rõ hơn sau khi làm trong lớp sừng. Một số cơ sở y tế sẽ kết hợp dùng nhiệt hoặc thuốc nhuộm hỗ trợ tăng độ tương phản giúp quan sát chính xác hơn.

3. Quan sát dưới kính hiển vi
Lam kính đã xử lý hoàn tất được đưa vào kính hiển vi quang học với độ phóng đại phù hợp từ 10x – 40x. Theo đó, bác sĩ lần lượt quan sát toàn bộ lam để tìm cấu trúc đặc trưng như sợi nấm dạng ống, bào tử nấm tròn, tế bào nấm men hoặc chuỗi giả sợi. Việc làm này cần thực hiện tỉ mỉ để tránh bỏ sót vùng có nấm, đồng thời phân biệt chính xác khuẩn nấm với mảnh vụn keratin hoặc tạp chất khác.
TÌM HIỂU NGAY: Bệnh nấm da có chữa được không?
4. Đọc kết quả soi tươi nấm
Mọi người có thể nhận được kết quả soi tươi vi nấm sau 5 – 15 phút thực hiện xét nghiệm giúp bác sĩ đưa ra hướng điều trị kịp thời:
- Âm tính: Không nhìn thấy sợi nấm hoặc bào tử trong mẫu. Tuy nhiên, kết quả âm tính chưa loại trừ hoàn toàn nhiễm nấm nên bác sĩ hoàn toàn có thể yêu cầu ngưng thuốc vài ngày hoặc chuyển sang nuôi cấy nếu nghi ngờ
- Dương tính: Quan sát thấy rõ sợi nấm, bào tử hoặc các cấu trúc đặc trưng của nấm. Khi đó, bác sĩ xác định vùng nhiễm nấm và đưa ra phác đồ điều trị phù hợp bao gồm sử dụng thuốc tại nhà kết hợp công nghệ hiện đại nếu nhiễm nấm nặng

IV. Xét nghiệm vi nấm soi tươi bao nhiêu tiền?
Hiện nay, chi phí xét nghiệm vi nấm soi tươi dao động từ 40.000 – 150.000 VNĐ/lần thực hiện. Đây là mức phí phải chăng với kỹ thuật cơ bản trong việc khám chữa bệnh da liễu. Tuy nhiên, chi phí thực tế có thể thay đổi phụ thuộc vào địa chỉ y tế thực hiện, kinh nghiệm bác sĩ, vị trí lấy mẫu, phương pháp hỗ trợ khác để tăng độ tương phản khi soi.
V. Lưu ý để đảm bảo độ chính xác của kết quả soi tươi nấm
Dưới đây là một số lưu ý quan trọng mà mọi người cần ghi nhớ trước và trong khi thực hiện xét nghiệm để kết quả soi tươi không bị sai lệch hoặc hiển thị âm tính giả:
1. Trước khi xét nghiệm
- Ngưng dùng các loại thuốc: Mọi người không bôi thoa hoặc uống thuốc kháng nấm, kháng sinh và corticoid trong 48 giờ trước khi làm xét nghiệm để tránh làm giảm số lượng nấm trên bề mặt da
- Không làm sạch sâu: Tuyệt đối không cắt mài móng, vệ sinh quá kỹ vùng da nghi ngờ khiến vô tình loại bỏ lớp vảy, mảnh vụn móng hoặc chất sừng chứa nhiều bào tử nấm
- Tránh cạy gãi mạnh tổn thương: Việc này làm trầy xước da khiến nấm bị phân tán nên khó thu được mẫu vật phẩm có bào tử nấm hoạt động mạnh nhất

2. Trong khi xét nghiệm
- Giữ yên vùng lấy mẫu: Chỉ cần cử động nhỏ cũng khiến mẫu bị lệch vị trí hoặc thu không đủ lượng làm giảm khả năng quan sát cấu trúc nấm
- Thông báo ngay khi bị đau: Một số vị trí như kẽ ngón, vùng móng hoặc da quá khô dễ gây đau khi lấy mẫu khiến mọi người phản xạ bất ngờ làm lấy lệch và sai vị trí mẫu bệnh
- Tuân thủ hướng dẫn: Mọi người tuyệt đối không chạm vào bệnh phẩm hoặc lam kính bởi dầu, bụi và vi khuẩn ở tay sẽ dính vào mẫu gây nhiễu, che mất cấu trúc nấm hoặc hình ảnh mờ, khó quan sát dẫn đến kết quả kém chính xác
VI. Địa chỉ làm xét nghiệm chẩn đoán vi nấm uy tín hiện nay
Trải qua hơn 16 năm hình thành và phát triển không ngừng nghỉ, Phòng khám Chuyên khoa Da liễu Maia&Maia tự hào là địa chỉ xét nghiệm và điều trị nấm da uy tín được đông đảo khách hàng tin tưởng lựa chọn bởi:
- Địa chỉ được cấp phép hoạt động bởi Sở Y Tế
- Sở hữu đội ngũ bác sĩ da liễu đầu ngành có trình độ chuyên môn tốt, giàu kinh nghiệm
- Cơ sở vật chất khang trang, đầu tư hệ thống trang thiết bị tân tiến phục vụ xét nghiệm vi nấm
- Quy trình thăm khám, xét nghiệm và chẩn đoán nấm da theo đúng tiêu chuẩn y khoa, đảm bảo độ chính xác cao
- Đội ngũ nhân viên tư vấn tận tâm, nhiệt tình giải đáp mọi thắc mắc của khách hàng

Bài viết trên đã mang đến cho mọi người những thông tin hữu ích về xét nghiệm vi nấm soi tươi và những lưu ý cần ghi nhớ để kết quả chính xác. Nếu đang gặp tình trạng nấm da và cần làm xét nghiệm cũng như điều trị, mọi người hãy liên hệ ngay với Phòng khám Chuyên khoa Da liễu Maia&Maia qua hotline 032.845.1188 để được tư vấn cụ thể.
TƯ VẤN 24/7 HOTLINE: 032.845.1188
Mọi thông tin của khách hàng đều được bảo mật
Phòng khám chuyên khoa Da liễu Maia&Maia:
- Facebook: Phòng khám Chuyên khoa Da liễu Maia&Maia
- Hotline: 18004888 và 032.845.1188
- Cơ sở 1: Số 11 Hoàng Cầu, Đống Đa, Hà Nội
- Cơ sở 2: Số 197 Lê Thánh Tông, Võ Cường, Bắc Ninh
- Cơ sở 3: Số 24 Nguyễn Khuyến, Hà Đông, Hà Nội